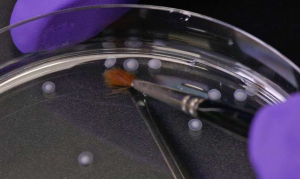
科学的力量：人工脑在培养皿中诞生了！

帕金森病 用血液和皮肤细胞培育的干细胞植入大脑,可治疗帕金森病
帕金森病 Parkinson s disease 是一种中枢神经退行性疾病 其主要症状有动作迟缓 身体僵硬 静止时震颤和拖步曳行等 其病因是由于患者们缺少生产多巴胺的细胞 而大脑需要多巴胺抑制小脑丘脑 关键词:干细胞...

帕金森病 Parkinson s disease 是一种中枢神经退行性疾病 其主要症状有动作迟缓 身体僵硬 静止时震颤和拖步曳行等 其病因是由于患者们缺少生产多巴胺的细胞 而大脑需要多巴胺抑制小脑丘脑 关键词:干细胞...
据法国媒体8月31日报道 日本研究人员日前发表报告指出 将取自人类干细胞制作的神经元 植入有帕金森氏病的实验室猴子的大脑后 猴子显著恢复了行动力 专家盛赞 这是 石破天惊 的研究成果 报道称 先前的研 关键词:多巴胺、胚胎...
来自哈佛大学 挪威卑尔根大学的研究人员通过分析1亿份挪威处方药单 发现哮喘药可以将患者发展为帕金森病的风险减少一半 这一研究成果公布在8月31日的Science杂志上 文章的通讯作者是哈佛大学教授Su 关键词:突触...

在国际空间站培育的LRRK2晶体将会进一步推进帕金森病药物治疗的研究 据悉 近日 有研究团队在国际空间站上进行一项特殊实验 目的是为了在太空环境中研制治疗帕金森氏病的新方法 这一研究将会为治疗帕金森提 关键词:基因、激酶...

英国 自然 杂志29日发表一项重要成果 日本科学家运用干细胞疗法 成功恢复了帕金森病猴模型的神经功能 这项研究表明 植入人诱导多能干细胞 iPSC 源多巴胺能神经元 可以改善病猴的运动能力 同一方法或 关键词:中脑...

伦敦大学学院领导的一项新研究发现 通常用于治疗糖尿病的药物艾塞那肽可能具有改善帕金森病的潜力 该研究发表The Lancet期刊上 研究发现 帕金森病患者每周注射艾塞那肽 持续1年后运动能力出现改善 关键词:神经元、TheLancet...

日前 一项刊登在国际杂志British Journal of Pharmacology上的研究报告中 来自宾汉顿大学的研究人员通过研究开发了一种限制帕金森疾病进展的新型药物 这种药物或有望帮助缓解成百 关键词:多巴胺、受体...
现在确实方便了 以前我那边一个病友为了报销看病费用 各种材料 各种盖章 从延安到西安来来回回跑了好几次 最后还是在我们当地报销的 现在 我在这边办完出院手续 在唐都医院就能直接报销了 帕金森病患者老宋 关键词:神经退行性疾病、神经外科...
一项新的研究显示 帕金森病人再患黑色素瘤皮肤癌的几率要比一般人高4倍 而黑色素瘤病人患帕金森病的风险也要比常人高4倍 梅奥医疗中心的达文 Lauren Dalvin 博士指出 未来的研究将主要确定可能 关键词:基因、癌症...
人体中最复杂的器官是大脑 由于其复杂性 当然 也出于道德原因 对其进行科学实验例如可以帮助我们了解帕金森病等神经变性疾病的实验是非常困难的 卢森堡大学卢森堡体系生物医学中心 LCSB 的科学家现在已经 关键词:中脑、干细胞...
新华社电 德国赫蒂临床脑研究所11月16日宣布 德...
摘要 美国食品药品监督管理局 FDA 近日批准了自...
帕金森病 PD 是一种常见的神经退行性疾病 影响着...
伦敦大学学院领导的一项新研究发现 通常用于治...
现在确实方便了 以前我那边一个病友为了报销看...
本报讯 记者日前从上海交通大学获悉 该校系统生...